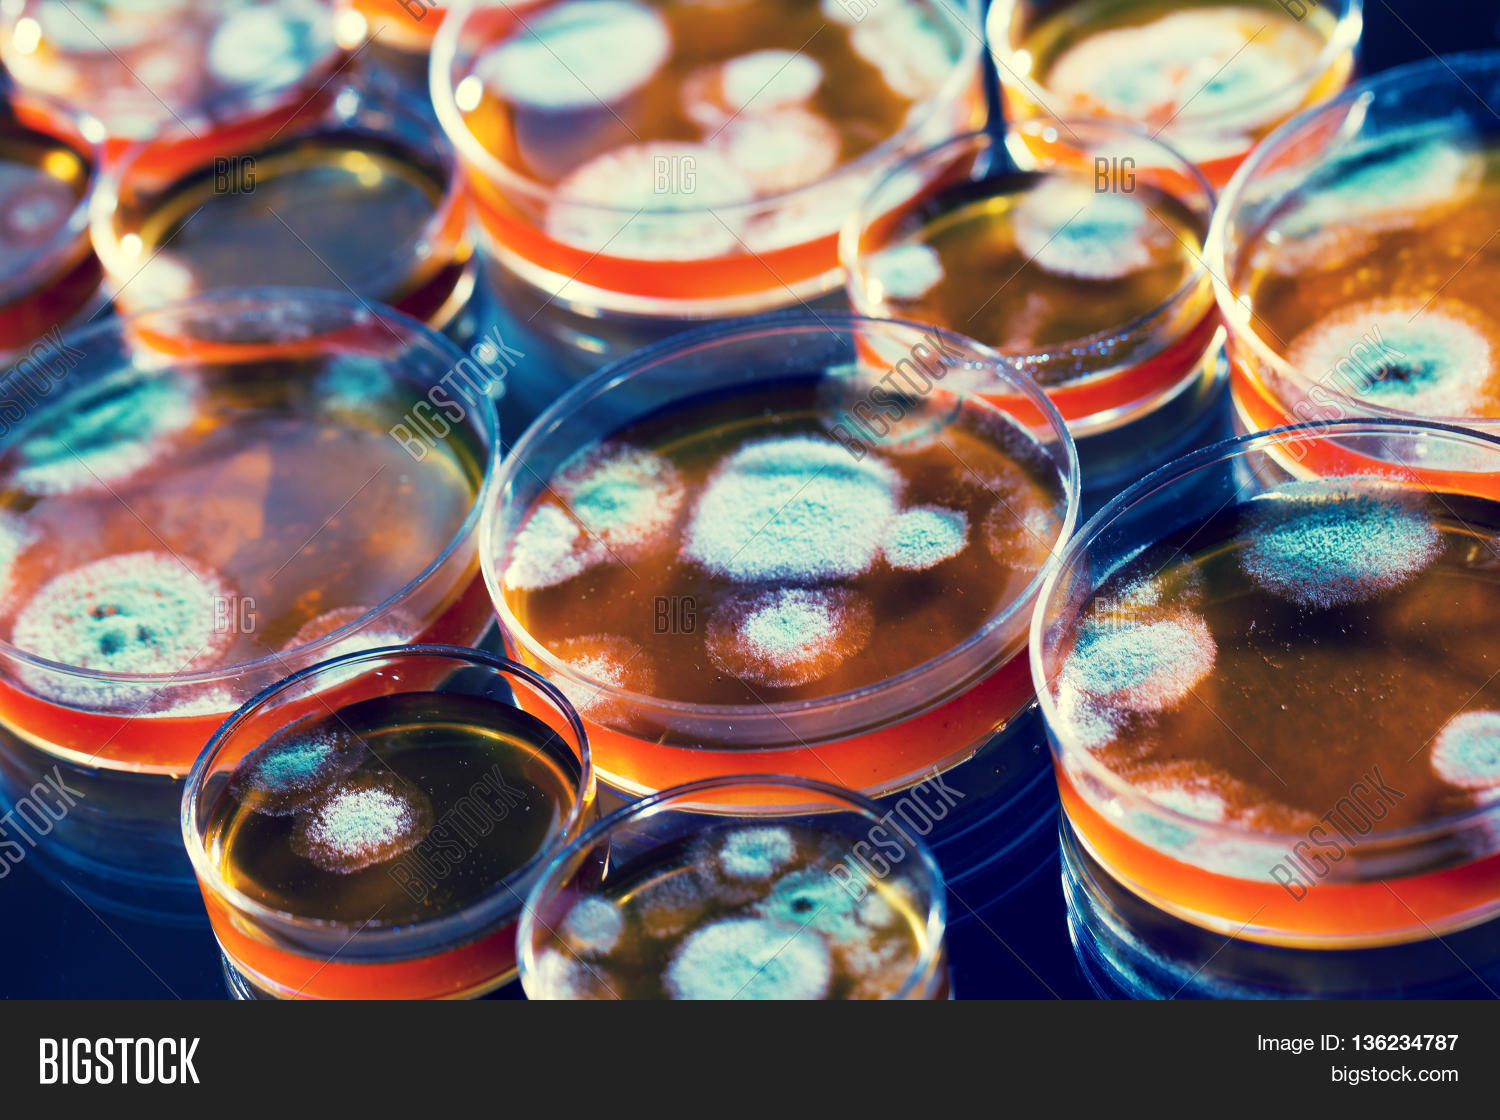
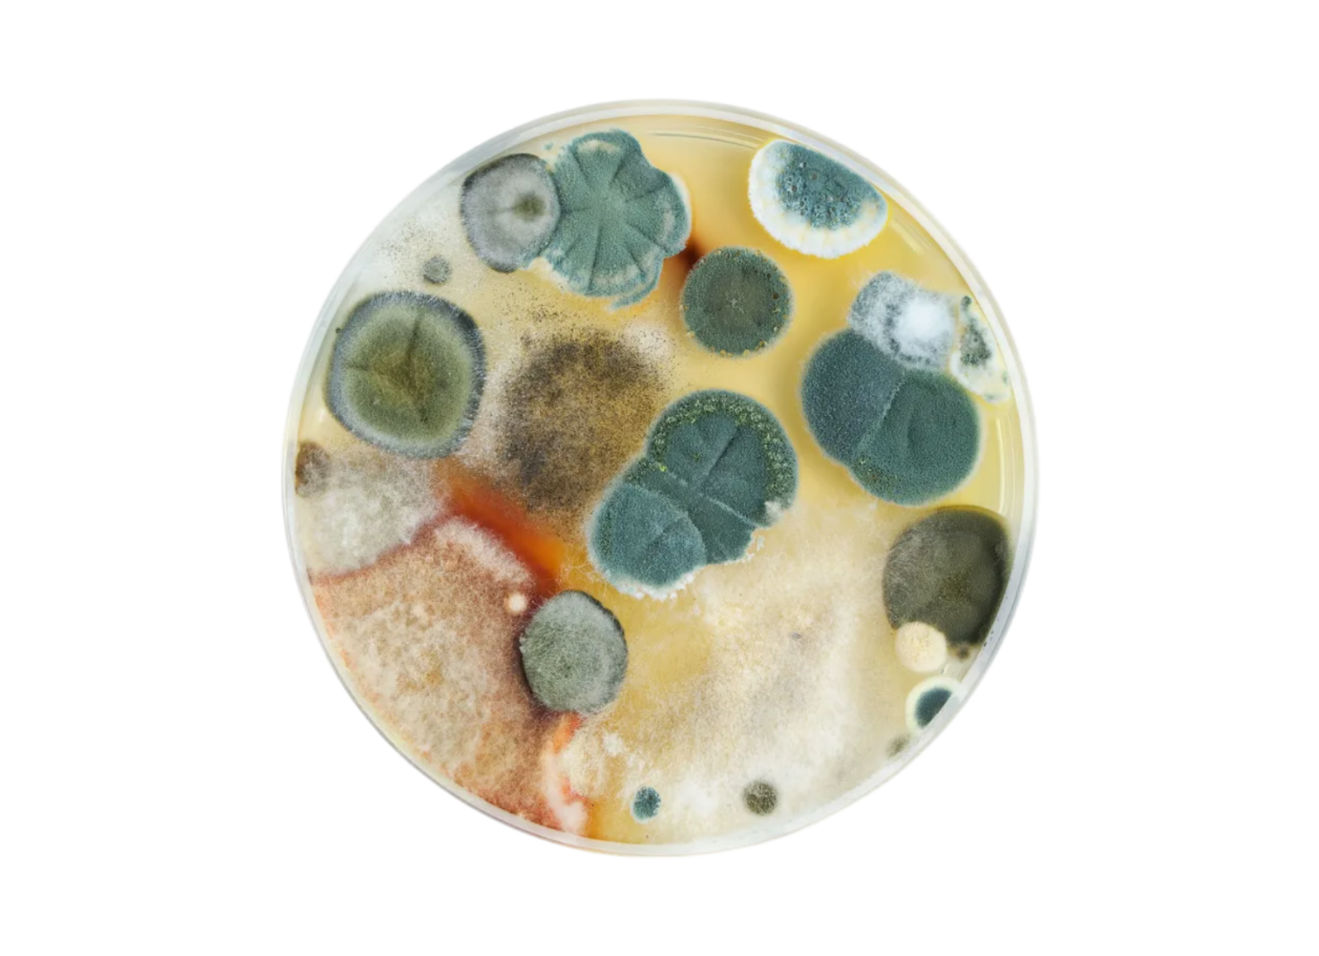
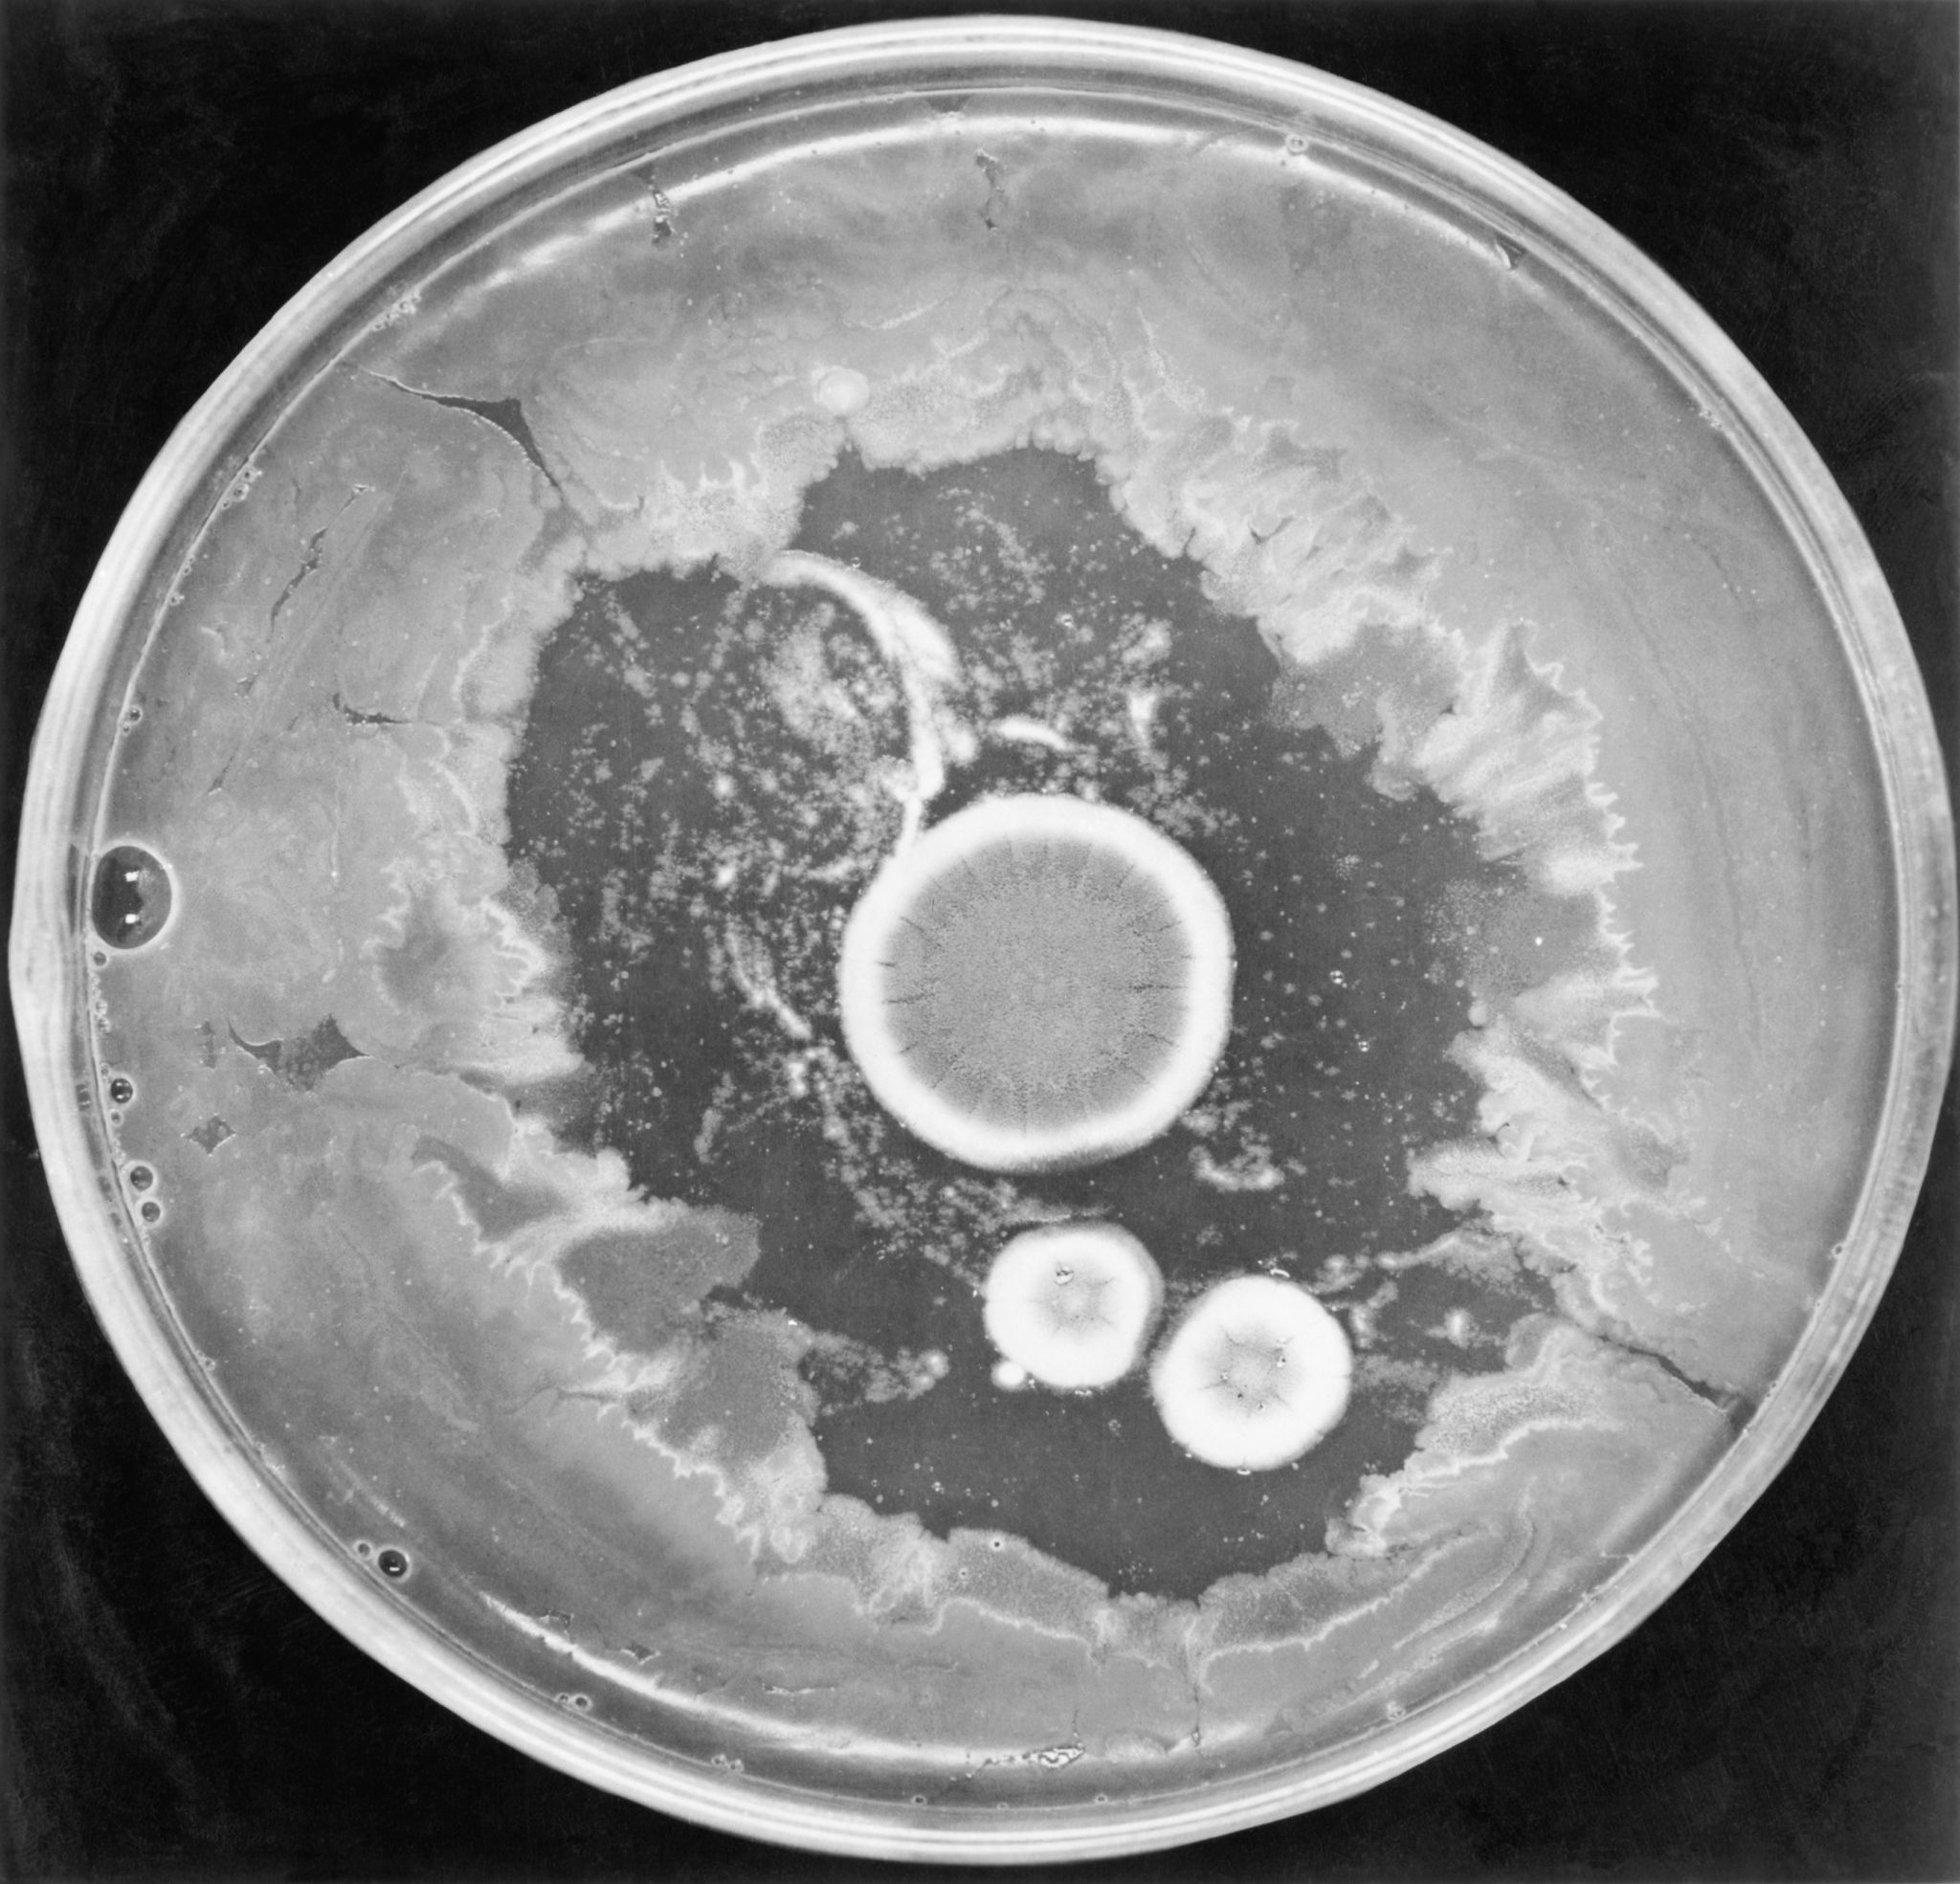
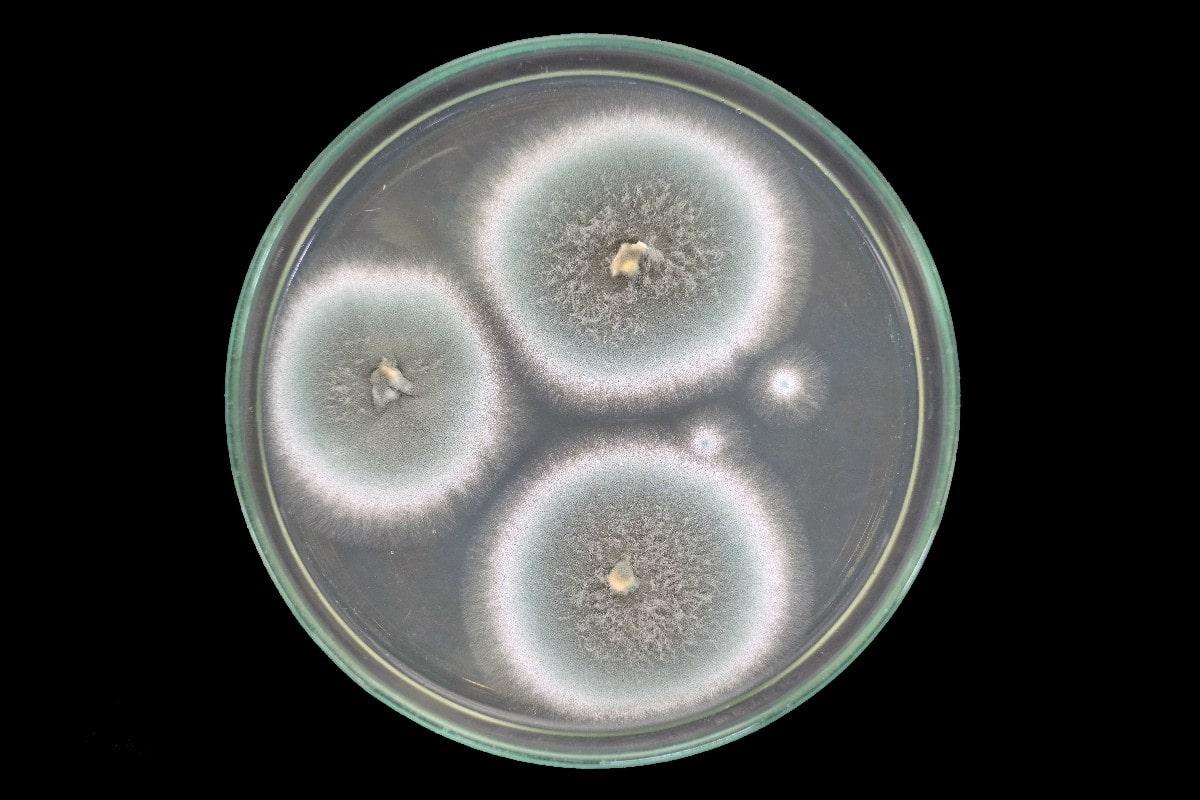

Чашка петри пеницилл
Подслушано в кировграде
Керлинг в сочи
Шерше ля шар
Магазин техники на гагарина
Страны африки на французском языке
Штатная магнитола универсальная
Miss valeria
Кто такие люди с севера
Слушать аудиокнигу звереныш книга 4
Снова замерло слова
Благотворительный фонд википедия
Какие дороги перекроют 14 сентября
Две квартиры в одном лицевом счете
Чашка петри пеницилл 113 фото